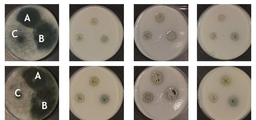
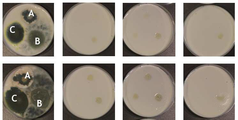
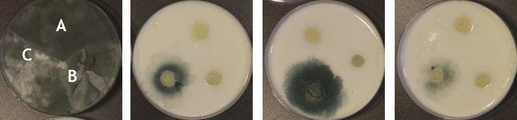
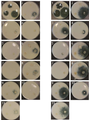

KR20180042407A - 항진균 활성을 갖는 락토바실러스 퍼멘텀 박테리아 - Google Patents
항진균 활성을 갖는 락토바실러스 퍼멘텀 박테리아 Download PDFInfo
- Publication number
- KR20180042407A KR20180042407A KR1020187008642A KR20187008642A KR20180042407A KR 20180042407 A KR20180042407 A KR 20180042407A KR 1020187008642 A KR1020187008642 A KR 1020187008642A KR 20187008642 A KR20187008642 A KR 20187008642A KR 20180042407 A KR20180042407 A KR 20180042407A
- Authority
- KR
- South Korea
- Prior art keywords
- lactobacillus
- lactobacillus fermentum
- concentration
- strain
- fermented milk
- Prior art date
- Legal status (The legal status is an assumption and is not a legal conclusion. Google has not performed a legal analysis and makes no representation as to the accuracy of the status listed.)
- Withdrawn
Links
- 241000186840 Lactobacillus fermentum Species 0.000 title claims abstract description 115
- 230000000843 anti-fungal effect Effects 0.000 title description 37
- 239000007858 starting material Substances 0.000 claims abstract description 122
- 229940012969 lactobacillus fermentum Drugs 0.000 claims abstract description 86
- 241000894006 Bacteria Species 0.000 claims abstract description 83
- 235000014048 cultured milk product Nutrition 0.000 claims abstract description 77
- 235000013336 milk Nutrition 0.000 claims abstract description 77
- 239000008267 milk Substances 0.000 claims abstract description 77
- 210000004080 milk Anatomy 0.000 claims abstract description 77
- 235000015140 cultured milk Nutrition 0.000 claims abstract description 35
- 238000004519 manufacturing process Methods 0.000 claims abstract description 34
- 239000000203 mixture Substances 0.000 claims abstract description 31
- 229920001817 Agar Polymers 0.000 claims abstract description 28
- 239000008272 agar Substances 0.000 claims abstract description 28
- 241000228143 Penicillium Species 0.000 claims abstract description 21
- 241000864268 Penicillium solitum Species 0.000 claims abstract description 20
- 230000035755 proliferation Effects 0.000 claims abstract description 20
- 238000003556 assay Methods 0.000 claims abstract description 18
- 230000005764 inhibitory process Effects 0.000 claims abstract description 15
- 230000002538 fungal effect Effects 0.000 claims abstract description 12
- 239000007787 solid Substances 0.000 claims abstract description 6
- 238000000855 fermentation Methods 0.000 claims description 85
- 230000004151 fermentation Effects 0.000 claims description 85
- IKHGUXGNUITLKF-UHFFFAOYSA-N Acetaldehyde Chemical compound CC=O IKHGUXGNUITLKF-UHFFFAOYSA-N 0.000 claims description 62
- 241000186660 Lactobacillus Species 0.000 claims description 50
- 229940039696 lactobacillus Drugs 0.000 claims description 43
- 238000000034 method Methods 0.000 claims description 31
- QSJXEFYPDANLFS-UHFFFAOYSA-N Diacetyl Chemical group CC(=O)C(C)=O QSJXEFYPDANLFS-UHFFFAOYSA-N 0.000 claims description 27
- 235000013305 food Nutrition 0.000 claims description 27
- 241000233866 Fungi Species 0.000 claims description 25
- JVTAAEKCZFNVCJ-UHFFFAOYSA-N lactic acid Chemical compound CC(O)C(O)=O JVTAAEKCZFNVCJ-UHFFFAOYSA-N 0.000 claims description 24
- 238000003860 storage Methods 0.000 claims description 22
- 241000894007 species Species 0.000 claims description 19
- 235000013365 dairy product Nutrition 0.000 claims description 18
- 238000003988 headspace gas chromatography Methods 0.000 claims description 18
- 230000003068 static effect Effects 0.000 claims description 17
- 241000186605 Lactobacillus paracasei Species 0.000 claims description 13
- 239000003814 drug Substances 0.000 claims description 12
- 235000014655 lactic acid Nutrition 0.000 claims description 12
- 239000004310 lactic acid Substances 0.000 claims description 12
- 230000035772 mutation Effects 0.000 claims description 12
- XLYOFNOQVPJJNP-UHFFFAOYSA-N water Substances O XLYOFNOQVPJJNP-UHFFFAOYSA-N 0.000 claims description 12
- 150000001875 compounds Chemical class 0.000 claims description 9
- 238000011282 treatment Methods 0.000 claims description 8
- 241000194036 Lactococcus Species 0.000 claims description 7
- 230000001332 colony forming effect Effects 0.000 claims description 7
- 241000194017 Streptococcus Species 0.000 claims description 6
- 238000009395 breeding Methods 0.000 claims description 6
- 230000001488 breeding effect Effects 0.000 claims description 6
- 241000192132 Leuconostoc Species 0.000 claims description 5
- 230000001965 increasing effect Effects 0.000 claims description 5
- 239000007788 liquid Substances 0.000 claims description 5
- 239000000463 material Substances 0.000 claims description 5
- 239000000126 substance Substances 0.000 claims description 5
- 230000001580 bacterial effect Effects 0.000 claims description 4
- 238000001816 cooling Methods 0.000 claims description 4
- 239000002304 perfume Substances 0.000 claims description 4
- 230000008569 process Effects 0.000 claims description 3
- 108010053481 Antifreeze Proteins Proteins 0.000 claims description 2
- 241000192001 Pediococcus Species 0.000 claims description 2
- 230000002528 anti-freeze Effects 0.000 claims description 2
- 238000007710 freezing Methods 0.000 claims description 2
- 230000008014 freezing Effects 0.000 claims description 2
- 241000228145 Penicillium brevicompactum Species 0.000 claims 1
- 229940098377 penicillium brevicompactum Drugs 0.000 claims 1
- 230000002401 inhibitory effect Effects 0.000 abstract description 13
- 239000000047 product Substances 0.000 description 37
- 235000013618 yogurt Nutrition 0.000 description 31
- 230000000694 effects Effects 0.000 description 21
- 238000004458 analytical method Methods 0.000 description 15
- 235000013351 cheese Nutrition 0.000 description 15
- 239000000356 contaminant Substances 0.000 description 15
- 239000003039 volatile agent Substances 0.000 description 13
- 230000020477 pH reduction Effects 0.000 description 12
- 230000004044 response Effects 0.000 description 12
- 241000194020 Streptococcus thermophilus Species 0.000 description 9
- 244000005700 microbiome Species 0.000 description 9
- 240000004808 Saccharomyces cerevisiae Species 0.000 description 8
- 229940121375 antifungal agent Drugs 0.000 description 8
- 230000000513 bioprotective effect Effects 0.000 description 8
- 235000020603 homogenised milk Nutrition 0.000 description 8
- 235000004213 low-fat Nutrition 0.000 description 8
- 238000002360 preparation method Methods 0.000 description 8
- 239000012925 reference material Substances 0.000 description 8
- 238000012764 semi-quantitative analysis Methods 0.000 description 8
- 239000000243 solution Substances 0.000 description 8
- 238000006243 chemical reaction Methods 0.000 description 6
- 238000012937 correction Methods 0.000 description 6
- 238000001514 detection method Methods 0.000 description 6
- 238000005516 engineering process Methods 0.000 description 6
- 238000004817 gas chromatography Methods 0.000 description 6
- 239000004615 ingredient Substances 0.000 description 6
- 239000013643 reference control Substances 0.000 description 6
- GUBGYTABKSRVRQ-QKKXKWKRSA-N Lactose Natural products OC[C@H]1O[C@@H](O[C@H]2[C@H](O)[C@@H](O)C(O)O[C@@H]2CO)[C@H](O)[C@@H](O)[C@H]1O GUBGYTABKSRVRQ-QKKXKWKRSA-N 0.000 description 5
- 244000233952 Polygonum bistorta Species 0.000 description 5
- 235000019197 fats Nutrition 0.000 description 5
- 239000000796 flavoring agent Substances 0.000 description 5
- 235000019634 flavors Nutrition 0.000 description 5
- 239000008101 lactose Substances 0.000 description 5
- 239000000725 suspension Substances 0.000 description 5
- 241000186000 Bifidobacterium Species 0.000 description 4
- 241000186673 Lactobacillus delbrueckii Species 0.000 description 4
- 229920002472 Starch Polymers 0.000 description 4
- 230000008901 benefit Effects 0.000 description 4
- 238000002474 experimental method Methods 0.000 description 4
- 230000000644 propagated effect Effects 0.000 description 4
- 230000001953 sensory effect Effects 0.000 description 4
- 235000019698 starch Nutrition 0.000 description 4
- 239000008107 starch Substances 0.000 description 4
- CSCPPACGZOOCGX-UHFFFAOYSA-N Acetone Chemical compound CC(C)=O CSCPPACGZOOCGX-UHFFFAOYSA-N 0.000 description 3
- 241000193830 Bacillus <bacterium> Species 0.000 description 3
- 241000186012 Bifidobacterium breve Species 0.000 description 3
- 241001337994 Cryptococcus <scale insect> Species 0.000 description 3
- 240000001046 Lactobacillus acidophilus Species 0.000 description 3
- 235000013956 Lactobacillus acidophilus Nutrition 0.000 description 3
- 244000057717 Streptococcus lactis Species 0.000 description 3
- 235000014897 Streptococcus lactis Nutrition 0.000 description 3
- 230000015572 biosynthetic process Effects 0.000 description 3
- 239000006071 cream Substances 0.000 description 3
- 235000013399 edible fruits Nutrition 0.000 description 3
- 229940039695 lactobacillus acidophilus Drugs 0.000 description 3
- 230000028327 secretion Effects 0.000 description 3
- 235000020183 skimmed milk Nutrition 0.000 description 3
- 239000000758 substrate Substances 0.000 description 3
- UHPMCKVQTMMPCG-UHFFFAOYSA-N 5,8-dihydroxy-2-methoxy-6-methyl-7-(2-oxopropyl)naphthalene-1,4-dione Chemical compound CC1=C(CC(C)=O)C(O)=C2C(=O)C(OC)=CC(=O)C2=C1O UHPMCKVQTMMPCG-UHFFFAOYSA-N 0.000 description 2
- 241000283690 Bos taurus Species 0.000 description 2
- 241000222120 Candida <Saccharomycetales> Species 0.000 description 2
- UDHXJZHVNHGCEC-UHFFFAOYSA-N Chlorophacinone Chemical compound C1=CC(Cl)=CC=C1C(C=1C=CC=CC=1)C(=O)C1C(=O)C2=CC=CC=C2C1=O UDHXJZHVNHGCEC-UHFFFAOYSA-N 0.000 description 2
- 241000235036 Debaryomyces hansenii Species 0.000 description 2
- 241000196324 Embryophyta Species 0.000 description 2
- 241000223218 Fusarium Species 0.000 description 2
- 240000006024 Lactobacillus plantarum Species 0.000 description 2
- 235000013965 Lactobacillus plantarum Nutrition 0.000 description 2
- 241000124008 Mammalia Species 0.000 description 2
- 240000000064 Penicillium roqueforti Species 0.000 description 2
- 244000253897 Saccharomyces delbrueckii Species 0.000 description 2
- 235000018370 Saccharomyces delbrueckii Nutrition 0.000 description 2
- FAPWRFPIFSIZLT-UHFFFAOYSA-M Sodium chloride Chemical compound [Na+].[Cl-] FAPWRFPIFSIZLT-UHFFFAOYSA-M 0.000 description 2
- MUMGGOZAMZWBJJ-DYKIIFRCSA-N Testostosterone Chemical compound O=C1CC[C@]2(C)[C@H]3CC[C@](C)([C@H](CC4)O)[C@@H]4[C@@H]3CCC2=C1 MUMGGOZAMZWBJJ-DYKIIFRCSA-N 0.000 description 2
- 235000014681 Torulaspora delbrueckii Nutrition 0.000 description 2
- 241000235013 Yarrowia Species 0.000 description 2
- 239000004480 active ingredient Substances 0.000 description 2
- 230000008859 change Effects 0.000 description 2
- 235000021001 fermented dairy product Nutrition 0.000 description 2
- 239000012467 final product Substances 0.000 description 2
- 229940072205 lactobacillus plantarum Drugs 0.000 description 2
- 235000020121 low-fat milk Nutrition 0.000 description 2
- 210000004698 lymphocyte Anatomy 0.000 description 2
- 230000002503 metabolic effect Effects 0.000 description 2
- 239000002207 metabolite Substances 0.000 description 2
- 231100000219 mutagenic Toxicity 0.000 description 2
- 230000003505 mutagenic effect Effects 0.000 description 2
- 239000002773 nucleotide Substances 0.000 description 2
- 125000003729 nucleotide group Chemical group 0.000 description 2
- 150000007524 organic acids Chemical class 0.000 description 2
- 235000005985 organic acids Nutrition 0.000 description 2
- 235000018102 proteins Nutrition 0.000 description 2
- 108090000623 proteins and genes Proteins 0.000 description 2
- 102000004169 proteins and genes Human genes 0.000 description 2
- 230000009467 reduction Effects 0.000 description 2
- 238000012216 screening Methods 0.000 description 2
- 230000002195 synergetic effect Effects 0.000 description 2
- SRKQWNFPTBNUKE-UHFFFAOYSA-N 1-methyl-1,2-dinitroguanidine Chemical compound [O-][N+](=O)N(C)\C(N)=N/[N+]([O-])=O SRKQWNFPTBNUKE-UHFFFAOYSA-N 0.000 description 1
- VNPMDUDIDCXVCH-UHFFFAOYSA-N 2-[4-[2-(2,3-dihydro-1H-inden-2-ylamino)pyrimidin-5-yl]-3-(3-piperazin-1-ylpropyl)pyrazol-1-yl]-1-(2,4,6,7-tetrahydrotriazolo[4,5-c]pyridin-5-yl)ethanone Chemical compound O=C(CN1C=C(C(CCCN2CCNCC2)=N1)C1=CN=C(NC2CC3=C(C2)C=CC=C3)N=C1)N1CCC2=C(C1)N=NN2 VNPMDUDIDCXVCH-UHFFFAOYSA-N 0.000 description 1
- 241000186425 Acidipropionibacterium jensenii Species 0.000 description 1
- 244000144725 Amygdalus communis Species 0.000 description 1
- 241000208223 Anacardiaceae Species 0.000 description 1
- 235000002198 Annona diversifolia Nutrition 0.000 description 1
- 244000105624 Arachis hypogaea Species 0.000 description 1
- 235000007319 Avena orientalis Nutrition 0.000 description 1
- 244000075850 Avena orientalis Species 0.000 description 1
- 241000304886 Bacilli Species 0.000 description 1
- 241001134770 Bifidobacterium animalis Species 0.000 description 1
- 241000282832 Camelidae Species 0.000 description 1
- 244000025254 Cannabis sativa Species 0.000 description 1
- 235000012766 Cannabis sativa ssp. sativa var. sativa Nutrition 0.000 description 1
- 235000012765 Cannabis sativa ssp. sativa var. spontanea Nutrition 0.000 description 1
- 241000283707 Capra Species 0.000 description 1
- 241000397426 Centroberyx lineatus Species 0.000 description 1
- 241000282994 Cervidae Species 0.000 description 1
- 240000006162 Chenopodium quinoa Species 0.000 description 1
- 241000222290 Cladosporium Species 0.000 description 1
- 244000060011 Cocos nucifera Species 0.000 description 1
- 235000013162 Cocos nucifera Nutrition 0.000 description 1
- 241000723382 Corylus Species 0.000 description 1
- 235000007466 Corylus avellana Nutrition 0.000 description 1
- 241000235035 Debaryomyces Species 0.000 description 1
- WQZGKKKJIJFFOK-GASJEMHNSA-N Glucose Natural products OC[C@H]1OC(O)[C@H](O)[C@@H](O)[C@@H]1O WQZGKKKJIJFFOK-GASJEMHNSA-N 0.000 description 1
- 240000005979 Hordeum vulgare Species 0.000 description 1
- 235000007340 Hordeum vulgare Nutrition 0.000 description 1
- 108010059881 Lactase Proteins 0.000 description 1
- 244000199885 Lactobacillus bulgaricus Species 0.000 description 1
- 235000013960 Lactobacillus bulgaricus Nutrition 0.000 description 1
- 241001147746 Lactobacillus delbrueckii subsp. lactis Species 0.000 description 1
- 240000002605 Lactobacillus helveticus Species 0.000 description 1
- 235000013967 Lactobacillus helveticus Nutrition 0.000 description 1
- 241000218588 Lactobacillus rhamnosus Species 0.000 description 1
- 241000282838 Lama Species 0.000 description 1
- 240000007594 Oryza sativa Species 0.000 description 1
- 235000007164 Oryza sativa Nutrition 0.000 description 1
- 241001494479 Pecora Species 0.000 description 1
- 229930182555 Penicillin Natural products 0.000 description 1
- JGSARLDLIJGVTE-MBNYWOFBSA-N Penicillin G Chemical compound N([C@H]1[C@H]2SC([C@@H](N2C1=O)C(O)=O)(C)C)C(=O)CC1=CC=CC=C1 JGSARLDLIJGVTE-MBNYWOFBSA-N 0.000 description 1
- 241001507662 Penicillium crustosum Species 0.000 description 1
- 241000960405 Penicillium paneum Species 0.000 description 1
- 244000046052 Phaseolus vulgaris Species 0.000 description 1
- 235000010627 Phaseolus vulgaris Nutrition 0.000 description 1
- 240000004713 Pisum sativum Species 0.000 description 1
- 235000010582 Pisum sativum Nutrition 0.000 description 1
- 244000000231 Sesamum indicum Species 0.000 description 1
- 235000003434 Sesamum indicum Nutrition 0.000 description 1
- 241000235015 Yarrowia lipolytica Species 0.000 description 1
- 239000002253 acid Substances 0.000 description 1
- 230000002378 acidificating effect Effects 0.000 description 1
- 235000020224 almond Nutrition 0.000 description 1
- WQZGKKKJIJFFOK-PHYPRBDBSA-N alpha-D-galactose Chemical compound OC[C@H]1O[C@H](O)[C@H](O)[C@@H](O)[C@H]1O WQZGKKKJIJFFOK-PHYPRBDBSA-N 0.000 description 1
- 230000000845 anti-microbial effect Effects 0.000 description 1
- QVGXLLKOCUKJST-UHFFFAOYSA-N atomic oxygen Chemical compound [O] QVGXLLKOCUKJST-UHFFFAOYSA-N 0.000 description 1
- 230000009286 beneficial effect Effects 0.000 description 1
- WQZGKKKJIJFFOK-VFUOTHLCSA-N beta-D-glucose Chemical compound OC[C@H]1O[C@@H](O)[C@H](O)[C@@H](O)[C@@H]1O WQZGKKKJIJFFOK-VFUOTHLCSA-N 0.000 description 1
- 108010005774 beta-Galactosidase Proteins 0.000 description 1
- 229940118852 bifidobacterium animalis Drugs 0.000 description 1
- 230000033228 biological regulation Effects 0.000 description 1
- 235000008429 bread Nutrition 0.000 description 1
- 239000012267 brine Substances 0.000 description 1
- 235000015155 buttermilk Nutrition 0.000 description 1
- 235000009120 camo Nutrition 0.000 description 1
- 229940041514 candida albicans extract Drugs 0.000 description 1
- 150000001720 carbohydrates Chemical class 0.000 description 1
- 235000014633 carbohydrates Nutrition 0.000 description 1
- 239000005018 casein Substances 0.000 description 1
- BECPQYXYKAMYBN-UHFFFAOYSA-N casein, tech. Chemical compound NCCCCC(C(O)=O)N=C(O)C(CC(O)=O)N=C(O)C(CCC(O)=N)N=C(O)C(CC(C)C)N=C(O)C(CCC(O)=O)N=C(O)C(CC(O)=O)N=C(O)C(CCC(O)=O)N=C(O)C(C(C)O)N=C(O)C(CCC(O)=N)N=C(O)C(CCC(O)=N)N=C(O)C(CCC(O)=N)N=C(O)C(CCC(O)=O)N=C(O)C(CCC(O)=O)N=C(O)C(COP(O)(O)=O)N=C(O)C(CCC(O)=N)N=C(O)C(N)CC1=CC=CC=C1 BECPQYXYKAMYBN-UHFFFAOYSA-N 0.000 description 1
- 235000021240 caseins Nutrition 0.000 description 1
- 235000020226 cashew nut Nutrition 0.000 description 1
- 238000005119 centrifugation Methods 0.000 description 1
- 235000013339 cereals Nutrition 0.000 description 1
- 235000005607 chanvre indien Nutrition 0.000 description 1
- 239000002962 chemical mutagen Substances 0.000 description 1
- 239000007795 chemical reaction product Substances 0.000 description 1
- 235000020379 cucumber juice Nutrition 0.000 description 1
- 235000015142 cultured sour cream Nutrition 0.000 description 1
- 238000011161 development Methods 0.000 description 1
- 201000010099 disease Diseases 0.000 description 1
- 208000037265 diseases, disorders, signs and symptoms Diseases 0.000 description 1
- 229940079593 drug Drugs 0.000 description 1
- 238000000909 electrodialysis Methods 0.000 description 1
- 239000000839 emulsion Substances 0.000 description 1
- 238000011156 evaluation Methods 0.000 description 1
- 235000021107 fermented food Nutrition 0.000 description 1
- 239000000835 fiber Substances 0.000 description 1
- 239000000945 filler Substances 0.000 description 1
- 235000013332 fish product Nutrition 0.000 description 1
- 235000003599 food sweetener Nutrition 0.000 description 1
- 235000015061 fromage frais Nutrition 0.000 description 1
- 238000010230 functional analysis Methods 0.000 description 1
- 229930182830 galactose Natural products 0.000 description 1
- 238000010353 genetic engineering Methods 0.000 description 1
- 239000008103 glucose Substances 0.000 description 1
- 235000011617 hard cheese Nutrition 0.000 description 1
- 238000010438 heat treatment Methods 0.000 description 1
- 239000011487 hemp Substances 0.000 description 1
- 238000000265 homogenisation Methods 0.000 description 1
- 230000007062 hydrolysis Effects 0.000 description 1
- 238000006460 hydrolysis reaction Methods 0.000 description 1
- 230000001976 improved effect Effects 0.000 description 1
- 230000001939 inductive effect Effects 0.000 description 1
- 238000011081 inoculation Methods 0.000 description 1
- 229910052500 inorganic mineral Inorganic materials 0.000 description 1
- 238000004255 ion exchange chromatography Methods 0.000 description 1
- 229940054346 lactobacillus helveticus Drugs 0.000 description 1
- 230000035800 maturation Effects 0.000 description 1
- 235000013372 meat Nutrition 0.000 description 1
- 235000021243 milk fat Nutrition 0.000 description 1
- 239000011707 mineral Substances 0.000 description 1
- 238000002156 mixing Methods 0.000 description 1
- 230000001473 noxious effect Effects 0.000 description 1
- 235000015097 nutrients Nutrition 0.000 description 1
- 239000001301 oxygen Substances 0.000 description 1
- 229910052760 oxygen Inorganic materials 0.000 description 1
- 238000009928 pasteurization Methods 0.000 description 1
- 244000052769 pathogen Species 0.000 description 1
- 235000020232 peanut Nutrition 0.000 description 1
- 229940049954 penicillin Drugs 0.000 description 1
- RLLPVAHGXHCWKJ-UHFFFAOYSA-N permethrin Chemical compound CC1(C)C(C=C(Cl)Cl)C1C(=O)OCC1=CC=CC(OC=2C=CC=CC=2)=C1 RLLPVAHGXHCWKJ-UHFFFAOYSA-N 0.000 description 1
- 229960000490 permethrin Drugs 0.000 description 1
- 239000010908 plant waste Substances 0.000 description 1
- 230000001737 promoting effect Effects 0.000 description 1
- 230000001902 propagating effect Effects 0.000 description 1
- 238000011321 prophylaxis Methods 0.000 description 1
- 230000005855 radiation Effects 0.000 description 1
- 235000009566 rice Nutrition 0.000 description 1
- 150000003839 salts Chemical class 0.000 description 1
- 235000013580 sausages Nutrition 0.000 description 1
- 210000002966 serum Anatomy 0.000 description 1
- 239000011780 sodium chloride Substances 0.000 description 1
- HPALAKNZSZLMCH-UHFFFAOYSA-M sodium;chloride;hydrate Chemical compound O.[Na+].[Cl-] HPALAKNZSZLMCH-UHFFFAOYSA-M 0.000 description 1
- 235000008983 soft cheese Nutrition 0.000 description 1
- 235000021262 sour milk Nutrition 0.000 description 1
- 239000003381 stabilizer Substances 0.000 description 1
- 235000000346 sugar Nutrition 0.000 description 1
- 235000020238 sunflower seed Nutrition 0.000 description 1
- 239000003765 sweetening agent Substances 0.000 description 1
- 238000012360 testing method Methods 0.000 description 1
- 229960003604 testosterone Drugs 0.000 description 1
- 239000002562 thickening agent Substances 0.000 description 1
- 235000013343 vitamin Nutrition 0.000 description 1
- 239000011782 vitamin Substances 0.000 description 1
- 229940088594 vitamin Drugs 0.000 description 1
- 229930003231 vitamin Natural products 0.000 description 1
- 235000008939 whole milk Nutrition 0.000 description 1
- 239000012138 yeast extract Substances 0.000 description 1
- 235000008924 yoghurt drink Nutrition 0.000 description 1
Images
Classifications
-
- A—HUMAN NECESSITIES
- A23—FOODS OR FOODSTUFFS; TREATMENT THEREOF, NOT COVERED BY OTHER CLASSES
- A23B—PRESERVATION OF FOODS, FOODSTUFFS OR NON-ALCOHOLIC BEVERAGES; CHEMICAL RIPENING OF FRUIT OR VEGETABLES
- A23B2/00—Preservation of foods or foodstuffs, in general
- A23B2/70—Preservation of foods or foodstuffs, in general by treatment with chemicals
- A23B2/725—Preservation of foods or foodstuffs, in general by treatment with chemicals in the form of liquids or solids
- A23B2/729—Organic compounds; Microorganisms; Enzymes
- A23B2/783—Microorganisms; Enzymes
-
- A—HUMAN NECESSITIES
- A23—FOODS OR FOODSTUFFS; TREATMENT THEREOF, NOT COVERED BY OTHER CLASSES
- A23C—DAIRY PRODUCTS, e.g. MILK, BUTTER OR CHEESE; MILK OR CHEESE SUBSTITUTES; MAKING OR TREATMENT THEREOF
- A23C9/00—Milk preparations; Milk powder or milk powder preparations
- A23C9/12—Fermented milk preparations; Treatment using microorganisms or enzymes
- A23C9/123—Fermented milk preparations; Treatment using microorganisms or enzymes using only microorganisms of the genus lactobacteriaceae; Yoghurt
-
- A—HUMAN NECESSITIES
- A23—FOODS OR FOODSTUFFS; TREATMENT THEREOF, NOT COVERED BY OTHER CLASSES
- A23C—DAIRY PRODUCTS, e.g. MILK, BUTTER OR CHEESE; MILK OR CHEESE SUBSTITUTES; MAKING OR TREATMENT THEREOF
- A23C9/00—Milk preparations; Milk powder or milk powder preparations
- A23C9/12—Fermented milk preparations; Treatment using microorganisms or enzymes
- A23C9/123—Fermented milk preparations; Treatment using microorganisms or enzymes using only microorganisms of the genus lactobacteriaceae; Yoghurt
- A23C9/1234—Fermented milk preparations; Treatment using microorganisms or enzymes using only microorganisms of the genus lactobacteriaceae; Yoghurt characterised by using a Lactobacillus sp. other than Lactobacillus Bulgaricus, including Bificlobacterium sp.
-
- A—HUMAN NECESSITIES
- A23—FOODS OR FOODSTUFFS; TREATMENT THEREOF, NOT COVERED BY OTHER CLASSES
- A23C—DAIRY PRODUCTS, e.g. MILK, BUTTER OR CHEESE; MILK OR CHEESE SUBSTITUTES; MAKING OR TREATMENT THEREOF
- A23C9/00—Milk preparations; Milk powder or milk powder preparations
- A23C9/12—Fermented milk preparations; Treatment using microorganisms or enzymes
- A23C9/123—Fermented milk preparations; Treatment using microorganisms or enzymes using only microorganisms of the genus lactobacteriaceae; Yoghurt
- A23C9/1236—Fermented milk preparations; Treatment using microorganisms or enzymes using only microorganisms of the genus lactobacteriaceae; Yoghurt using Leuconostoc, Pediococcus or Streptococcus sp. other than Streptococcus Thermophilus; Artificial sour buttermilk in general
-
- A—HUMAN NECESSITIES
- A23—FOODS OR FOODSTUFFS; TREATMENT THEREOF, NOT COVERED BY OTHER CLASSES
- A23C—DAIRY PRODUCTS, e.g. MILK, BUTTER OR CHEESE; MILK OR CHEESE SUBSTITUTES; MAKING OR TREATMENT THEREOF
- A23C9/00—Milk preparations; Milk powder or milk powder preparations
- A23C9/12—Fermented milk preparations; Treatment using microorganisms or enzymes
- A23C9/123—Fermented milk preparations; Treatment using microorganisms or enzymes using only microorganisms of the genus lactobacteriaceae; Yoghurt
- A23C9/1238—Fermented milk preparations; Treatment using microorganisms or enzymes using only microorganisms of the genus lactobacteriaceae; Yoghurt using specific L. bulgaricus or S. thermophilus microorganisms; using entrapped or encapsulated yoghurt bacteria; Physical or chemical treatment of L. bulgaricus or S. thermophilus cultures; Fermentation only with L. bulgaricus or only with S. thermophilus
-
- A—HUMAN NECESSITIES
- A23—FOODS OR FOODSTUFFS; TREATMENT THEREOF, NOT COVERED BY OTHER CLASSES
- A23K—FODDER
- A23K10/00—Animal feeding-stuffs
- A23K10/10—Animal feeding-stuffs obtained by microbiological or biochemical processes
- A23K10/16—Addition of microorganisms or extracts thereof, e.g. single-cell proteins, to feeding-stuff compositions
- A23K10/18—Addition of microorganisms or extracts thereof, e.g. single-cell proteins, to feeding-stuff compositions of live microorganisms
-
- A—HUMAN NECESSITIES
- A23—FOODS OR FOODSTUFFS; TREATMENT THEREOF, NOT COVERED BY OTHER CLASSES
- A23L—FOODS, FOODSTUFFS OR NON-ALCOHOLIC BEVERAGES, NOT OTHERWISE PROVIDED FOR; PREPARATION OR TREATMENT THEREOF
- A23L29/00—Foods or foodstuffs containing additives; Preparation or treatment thereof
-
- A—HUMAN NECESSITIES
- A23—FOODS OR FOODSTUFFS; TREATMENT THEREOF, NOT COVERED BY OTHER CLASSES
- A23L—FOODS, FOODSTUFFS OR NON-ALCOHOLIC BEVERAGES, NOT OTHERWISE PROVIDED FOR; PREPARATION OR TREATMENT THEREOF
- A23L33/00—Modifying nutritive qualities of foods; Dietetic products; Preparation or treatment thereof
- A23L33/10—Modifying nutritive qualities of foods; Dietetic products; Preparation or treatment thereof using additives
- A23L33/135—Bacteria or derivatives thereof, e.g. probiotics
-
- A—HUMAN NECESSITIES
- A61—MEDICAL OR VETERINARY SCIENCE; HYGIENE
- A61K—PREPARATIONS FOR MEDICAL, DENTAL OR TOILETRY PURPOSES
- A61K35/00—Medicinal preparations containing materials or reaction products thereof with undetermined constitution
- A61K35/66—Microorganisms or materials therefrom
- A61K35/74—Bacteria
- A61K35/741—Probiotics
- A61K35/744—Lactic acid bacteria, e.g. enterococci, pediococci, lactococci, streptococci or leuconostocs
- A61K35/747—Lactobacilli, e.g. L. acidophilus or L. brevis
-
- A—HUMAN NECESSITIES
- A61—MEDICAL OR VETERINARY SCIENCE; HYGIENE
- A61P—SPECIFIC THERAPEUTIC ACTIVITY OF CHEMICAL COMPOUNDS OR MEDICINAL PREPARATIONS
- A61P31/00—Antiinfectives, i.e. antibiotics, antiseptics, chemotherapeutics
- A61P31/04—Antibacterial agents
-
- A—HUMAN NECESSITIES
- A61—MEDICAL OR VETERINARY SCIENCE; HYGIENE
- A61P—SPECIFIC THERAPEUTIC ACTIVITY OF CHEMICAL COMPOUNDS OR MEDICINAL PREPARATIONS
- A61P31/00—Antiinfectives, i.e. antibiotics, antiseptics, chemotherapeutics
- A61P31/10—Antimycotics
-
- C—CHEMISTRY; METALLURGY
- C12—BIOCHEMISTRY; BEER; SPIRITS; WINE; VINEGAR; MICROBIOLOGY; ENZYMOLOGY; MUTATION OR GENETIC ENGINEERING
- C12N—MICROORGANISMS OR ENZYMES; COMPOSITIONS THEREOF; PROPAGATING, PRESERVING, OR MAINTAINING MICROORGANISMS; MUTATION OR GENETIC ENGINEERING; CULTURE MEDIA
- C12N1/00—Microorganisms, e.g. protozoa; Compositions thereof; Processes of propagating, maintaining or preserving microorganisms or compositions thereof; Processes of preparing or isolating a composition containing a microorganism; Culture media therefor
- C12N1/20—Bacteria; Culture media therefor
-
- C—CHEMISTRY; METALLURGY
- C12—BIOCHEMISTRY; BEER; SPIRITS; WINE; VINEGAR; MICROBIOLOGY; ENZYMOLOGY; MUTATION OR GENETIC ENGINEERING
- C12N—MICROORGANISMS OR ENZYMES; COMPOSITIONS THEREOF; PROPAGATING, PRESERVING, OR MAINTAINING MICROORGANISMS; MUTATION OR GENETIC ENGINEERING; CULTURE MEDIA
- C12N1/00—Microorganisms, e.g. protozoa; Compositions thereof; Processes of propagating, maintaining or preserving microorganisms or compositions thereof; Processes of preparing or isolating a composition containing a microorganism; Culture media therefor
- C12N1/20—Bacteria; Culture media therefor
- C12N1/205—Bacterial isolates
-
- A—HUMAN NECESSITIES
- A23—FOODS OR FOODSTUFFS; TREATMENT THEREOF, NOT COVERED BY OTHER CLASSES
- A23V—INDEXING SCHEME RELATING TO FOODS, FOODSTUFFS OR NON-ALCOHOLIC BEVERAGES AND LACTIC OR PROPIONIC ACID BACTERIA USED IN FOODSTUFFS OR FOOD PREPARATION
- A23V2002/00—Food compositions, function of food ingredients or processes for food or foodstuffs
-
- A—HUMAN NECESSITIES
- A23—FOODS OR FOODSTUFFS; TREATMENT THEREOF, NOT COVERED BY OTHER CLASSES
- A23V—INDEXING SCHEME RELATING TO FOODS, FOODSTUFFS OR NON-ALCOHOLIC BEVERAGES AND LACTIC OR PROPIONIC ACID BACTERIA USED IN FOODSTUFFS OR FOOD PREPARATION
- A23V2200/00—Function of food ingredients
- A23V2200/10—Preserving against microbes
-
- A—HUMAN NECESSITIES
- A23—FOODS OR FOODSTUFFS; TREATMENT THEREOF, NOT COVERED BY OTHER CLASSES
- A23V—INDEXING SCHEME RELATING TO FOODS, FOODSTUFFS OR NON-ALCOHOLIC BEVERAGES AND LACTIC OR PROPIONIC ACID BACTERIA USED IN FOODSTUFFS OR FOOD PREPARATION
- A23V2400/00—Lactic or propionic acid bacteria
- A23V2400/11—Lactobacillus
- A23V2400/113—Acidophilus
-
- A—HUMAN NECESSITIES
- A23—FOODS OR FOODSTUFFS; TREATMENT THEREOF, NOT COVERED BY OTHER CLASSES
- A23V—INDEXING SCHEME RELATING TO FOODS, FOODSTUFFS OR NON-ALCOHOLIC BEVERAGES AND LACTIC OR PROPIONIC ACID BACTERIA USED IN FOODSTUFFS OR FOOD PREPARATION
- A23V2400/00—Lactic or propionic acid bacteria
- A23V2400/11—Lactobacillus
- A23V2400/137—Delbrueckii
-
- A—HUMAN NECESSITIES
- A23—FOODS OR FOODSTUFFS; TREATMENT THEREOF, NOT COVERED BY OTHER CLASSES
- A23V—INDEXING SCHEME RELATING TO FOODS, FOODSTUFFS OR NON-ALCOHOLIC BEVERAGES AND LACTIC OR PROPIONIC ACID BACTERIA USED IN FOODSTUFFS OR FOOD PREPARATION
- A23V2400/00—Lactic or propionic acid bacteria
- A23V2400/11—Lactobacillus
- A23V2400/143—Fermentum
-
- A—HUMAN NECESSITIES
- A23—FOODS OR FOODSTUFFS; TREATMENT THEREOF, NOT COVERED BY OTHER CLASSES
- A23V—INDEXING SCHEME RELATING TO FOODS, FOODSTUFFS OR NON-ALCOHOLIC BEVERAGES AND LACTIC OR PROPIONIC ACID BACTERIA USED IN FOODSTUFFS OR FOOD PREPARATION
- A23V2400/00—Lactic or propionic acid bacteria
- A23V2400/11—Lactobacillus
- A23V2400/147—Helveticus
-
- A—HUMAN NECESSITIES
- A23—FOODS OR FOODSTUFFS; TREATMENT THEREOF, NOT COVERED BY OTHER CLASSES
- A23V—INDEXING SCHEME RELATING TO FOODS, FOODSTUFFS OR NON-ALCOHOLIC BEVERAGES AND LACTIC OR PROPIONIC ACID BACTERIA USED IN FOODSTUFFS OR FOOD PREPARATION
- A23V2400/00—Lactic or propionic acid bacteria
- A23V2400/11—Lactobacillus
- A23V2400/157—Lactis
-
- A—HUMAN NECESSITIES
- A23—FOODS OR FOODSTUFFS; TREATMENT THEREOF, NOT COVERED BY OTHER CLASSES
- A23V—INDEXING SCHEME RELATING TO FOODS, FOODSTUFFS OR NON-ALCOHOLIC BEVERAGES AND LACTIC OR PROPIONIC ACID BACTERIA USED IN FOODSTUFFS OR FOOD PREPARATION
- A23V2400/00—Lactic or propionic acid bacteria
- A23V2400/11—Lactobacillus
- A23V2400/165—Paracasei
-
- A—HUMAN NECESSITIES
- A23—FOODS OR FOODSTUFFS; TREATMENT THEREOF, NOT COVERED BY OTHER CLASSES
- A23V—INDEXING SCHEME RELATING TO FOODS, FOODSTUFFS OR NON-ALCOHOLIC BEVERAGES AND LACTIC OR PROPIONIC ACID BACTERIA USED IN FOODSTUFFS OR FOOD PREPARATION
- A23V2400/00—Lactic or propionic acid bacteria
- A23V2400/11—Lactobacillus
- A23V2400/169—Plantarum
-
- A—HUMAN NECESSITIES
- A23—FOODS OR FOODSTUFFS; TREATMENT THEREOF, NOT COVERED BY OTHER CLASSES
- A23V—INDEXING SCHEME RELATING TO FOODS, FOODSTUFFS OR NON-ALCOHOLIC BEVERAGES AND LACTIC OR PROPIONIC ACID BACTERIA USED IN FOODSTUFFS OR FOOD PREPARATION
- A23V2400/00—Lactic or propionic acid bacteria
- A23V2400/11—Lactobacillus
- A23V2400/175—Rhamnosus
-
- A—HUMAN NECESSITIES
- A23—FOODS OR FOODSTUFFS; TREATMENT THEREOF, NOT COVERED BY OTHER CLASSES
- A23V—INDEXING SCHEME RELATING TO FOODS, FOODSTUFFS OR NON-ALCOHOLIC BEVERAGES AND LACTIC OR PROPIONIC ACID BACTERIA USED IN FOODSTUFFS OR FOOD PREPARATION
- A23V2400/00—Lactic or propionic acid bacteria
- A23V2400/21—Streptococcus, lactococcus
- A23V2400/215—Cremoris
-
- A—HUMAN NECESSITIES
- A23—FOODS OR FOODSTUFFS; TREATMENT THEREOF, NOT COVERED BY OTHER CLASSES
- A23V—INDEXING SCHEME RELATING TO FOODS, FOODSTUFFS OR NON-ALCOHOLIC BEVERAGES AND LACTIC OR PROPIONIC ACID BACTERIA USED IN FOODSTUFFS OR FOOD PREPARATION
- A23V2400/00—Lactic or propionic acid bacteria
- A23V2400/21—Streptococcus, lactococcus
- A23V2400/249—Thermophilus
-
- A—HUMAN NECESSITIES
- A23—FOODS OR FOODSTUFFS; TREATMENT THEREOF, NOT COVERED BY OTHER CLASSES
- A23V—INDEXING SCHEME RELATING TO FOODS, FOODSTUFFS OR NON-ALCOHOLIC BEVERAGES AND LACTIC OR PROPIONIC ACID BACTERIA USED IN FOODSTUFFS OR FOOD PREPARATION
- A23V2400/00—Lactic or propionic acid bacteria
- A23V2400/31—Leuconostoc
-
- A—HUMAN NECESSITIES
- A23—FOODS OR FOODSTUFFS; TREATMENT THEREOF, NOT COVERED BY OTHER CLASSES
- A23V—INDEXING SCHEME RELATING TO FOODS, FOODSTUFFS OR NON-ALCOHOLIC BEVERAGES AND LACTIC OR PROPIONIC ACID BACTERIA USED IN FOODSTUFFS OR FOOD PREPARATION
- A23V2400/00—Lactic or propionic acid bacteria
- A23V2400/51—Bifidobacterium
- A23V2400/519—Breve
-
- A23Y2220/35—
-
- C12R1/225—
-
- C—CHEMISTRY; METALLURGY
- C12—BIOCHEMISTRY; BEER; SPIRITS; WINE; VINEGAR; MICROBIOLOGY; ENZYMOLOGY; MUTATION OR GENETIC ENGINEERING
- C12R—INDEXING SCHEME ASSOCIATED WITH SUBCLASSES C12C - C12Q, RELATING TO MICROORGANISMS
- C12R2001/00—Microorganisms ; Processes using microorganisms
- C12R2001/01—Bacteria or Actinomycetales ; using bacteria or Actinomycetales
- C12R2001/225—Lactobacillus
Landscapes
- Life Sciences & Earth Sciences (AREA)
- Health & Medical Sciences (AREA)
- Chemical & Material Sciences (AREA)
- Engineering & Computer Science (AREA)
- Microbiology (AREA)
- Zoology (AREA)
- Biotechnology (AREA)
- Polymers & Plastics (AREA)
- Organic Chemistry (AREA)
- Wood Science & Technology (AREA)
- Genetics & Genomics (AREA)
- Bioinformatics & Cheminformatics (AREA)
- Food Science & Technology (AREA)
- General Health & Medical Sciences (AREA)
- Medicinal Chemistry (AREA)
- Mycology (AREA)
- Biochemistry (AREA)
- Biomedical Technology (AREA)
- Virology (AREA)
- Tropical Medicine & Parasitology (AREA)
- General Engineering & Computer Science (AREA)
- Molecular Biology (AREA)
- Veterinary Medicine (AREA)
- Public Health (AREA)
- Animal Behavior & Ethology (AREA)
- Pharmacology & Pharmacy (AREA)
- Nutrition Science (AREA)
- Epidemiology (AREA)
- Physiology (AREA)
- Animal Husbandry (AREA)
- General Chemical & Material Sciences (AREA)
- Communicable Diseases (AREA)
- Oncology (AREA)
- Chemical Kinetics & Catalysis (AREA)
- Nuclear Medicine, Radiotherapy & Molecular Imaging (AREA)
- Micro-Organisms Or Cultivation Processes Thereof (AREA)
- Dairy Products (AREA)
- Medicines Containing Material From Animals Or Micro-Organisms (AREA)
- Coloring Foods And Improving Nutritive Qualities (AREA)
- Fodder In General (AREA)
Applications Claiming Priority (3)
| Application Number | Priority Date | Filing Date | Title |
|---|---|---|---|
| EP15183198 | 2015-08-31 | ||
| EP15183198.9 | 2015-08-31 | ||
| PCT/EP2016/070381 WO2017037046A1 (en) | 2015-08-31 | 2016-08-30 | Lactobacillus fermentum bacteria with antifungal activity |
Related Child Applications (1)
| Application Number | Title | Priority Date | Filing Date |
|---|---|---|---|
| KR1020187025725A Division KR20180101636A (ko) | 2015-08-31 | 2016-08-30 | 항진균 활성을 갖는 락토바실러스 퍼멘텀 박테리아 |
Publications (1)
| Publication Number | Publication Date |
|---|---|
| KR20180042407A true KR20180042407A (ko) | 2018-04-25 |
Family
ID=56852257
Family Applications (2)
| Application Number | Title | Priority Date | Filing Date |
|---|---|---|---|
| KR1020187008642A Withdrawn KR20180042407A (ko) | 2015-08-31 | 2016-08-30 | 항진균 활성을 갖는 락토바실러스 퍼멘텀 박테리아 |
| KR1020187025725A Ceased KR20180101636A (ko) | 2015-08-31 | 2016-08-30 | 항진균 활성을 갖는 락토바실러스 퍼멘텀 박테리아 |
Family Applications After (1)
| Application Number | Title | Priority Date | Filing Date |
|---|---|---|---|
| KR1020187025725A Ceased KR20180101636A (ko) | 2015-08-31 | 2016-08-30 | 항진균 활성을 갖는 락토바실러스 퍼멘텀 박테리아 |
Country Status (15)
Families Citing this family (17)
| Publication number | Priority date | Publication date | Assignee | Title |
|---|---|---|---|---|
| US20180235248A1 (en) * | 2015-08-31 | 2018-08-23 | Chr. Hansen A/S | Lactobacillus fermentum bacteria inhibiting post-acidification |
| EP3344749A1 (en) | 2015-08-31 | 2018-07-11 | Chr. Hansen A/S | Lactobacillus fermentum bacteria with antifungal activity |
| BR112018003474A2 (pt) * | 2015-08-31 | 2018-09-25 | Chr Hansen As | bactérias lactobacillus fermentum que reduzem a concentração de acetaldeído |
| CN111315225B (zh) * | 2017-10-27 | 2022-11-29 | 科·汉森有限公司 | 双乙酰产量增加的鼠李糖乳杆菌 |
| AU2019254580B2 (en) * | 2018-04-19 | 2023-11-09 | Chr. Hansen A/S | Inhibition of fungal growth by manganese depletion |
| CN109370948B (zh) * | 2018-11-26 | 2020-08-04 | 江南大学 | 一株高产6-磷酸-β-半乳糖苷酶的乳酸乳球菌及其应用 |
| JP2022553396A (ja) * | 2019-10-23 | 2022-12-22 | セーホーエル.ハンセン アクティーゼルスカブ | 真菌による腐敗を制御するための細菌組成物およびその使用 |
| CN111647521A (zh) * | 2020-04-02 | 2020-09-11 | 玉林市容县奇昌种猪养殖有限公司 | 一种乳杆菌gm_1及其选育方法 |
| PE20230445A1 (es) | 2020-04-16 | 2023-03-08 | Chr Hansen As | Metodo para reducir el crecimiento de listeria en productos alimenticios |
| US20230189831A1 (en) * | 2020-05-29 | 2023-06-22 | Chr. Hansen A/S | Bioprotective lactic acid bacteria with low postacidification |
| US12011011B2 (en) | 2020-07-27 | 2024-06-18 | Sargento Cheese Inc. | Natural cheese and method for making natural cheese with specific texture attributes |
| US11510416B1 (en) | 2021-02-18 | 2022-11-29 | Sargento Foods Inc. | Natural pasta-filata style cheese with improved texture |
| JP7207804B1 (ja) | 2022-10-23 | 2023-01-18 | 規雄 酒井 | 乳酸菌株、乳酸菌の取得方法、ヨーグルトの製造方法、ヨーグルトのスターター、ヨーグルトおよび乳酸菌発酵豆乳食品 |
| CN118580983A (zh) * | 2023-03-01 | 2024-09-03 | 重庆市天友乳业股份有限公司 | 发酵乳杆菌ty-f13及其应用 |
| WO2025132777A1 (en) | 2023-12-22 | 2025-06-26 | Chr. Hansen A/S | Method for producing a fermented milk product |
| CN117736930A (zh) * | 2023-12-28 | 2024-03-22 | 善恩康生物科技(苏州)有限公司 | 直投式酸奶发酵剂及制备方法 |
| CN120519321A (zh) * | 2025-05-07 | 2025-08-22 | 大连工业大学 | 一种利用细菌-真菌共培养对低盐发酵水产品的风味补偿方法及应用 |
Family Cites Families (19)
| Publication number | Priority date | Publication date | Assignee | Title |
|---|---|---|---|---|
| US4956177A (en) | 1985-11-04 | 1990-09-11 | Microlife Technics, Inc. | Method for inhibiting fungi |
| FI92498C (fi) | 1992-06-10 | 1994-11-25 | Valio Meijerien | Uusi mikro-organismikanta, sitä sisältävät bakteerivalmisteet ja näiden käyttö hiivojen ja homeiden torjuntaan |
| EP1308506A1 (en) | 2001-11-06 | 2003-05-07 | Eidgenössische Technische Hochschule Zürich | Mixtures of Propionibacterium jensenii and Lactobacillus sp. with antimicrobial activities for use as a natural preservation system |
| JP2004236638A (ja) | 2003-02-10 | 2004-08-26 | Taiyo Corp | 発酵乳乳清発酵液の製造法 |
| ITMI20062451A1 (it) * | 2006-12-20 | 2008-06-21 | Mofin S R L | Metodo per la preparazione di un latte destinato ad applicazioni lattiero-casearie il latte ottenuto con detto metodo ed i suoi usi |
| CN101273737B (zh) * | 2007-03-28 | 2011-08-24 | 哈尔滨正方科技有限公司 | 一种在常温下保持高活菌数的发酵乳饮料的制备方法 |
| TW200927141A (en) * | 2007-11-22 | 2009-07-01 | Bayer Schering Pharma Oy | Vaginal delivery system |
| JP2012531189A (ja) * | 2009-06-30 | 2012-12-10 | セーホーエル.ハンセン アクティーゼルスカブ | 発酵乳製品の生産のための方法 |
| IT1405780B1 (it) | 2010-07-12 | 2014-01-24 | Giuliani Spa | Miscela arricchita di isoflavoni-agliconi, equolo e lunasina a base di soia fermentata, procedimento per la sua preparazione e relativi usi in campo alimentare, medico e cosmetico. |
| US20140004083A1 (en) * | 2010-12-23 | 2014-01-02 | Dupont Nutrition Biosciences Aps | Cryoprotective compositions and uses thereof |
| EA028377B1 (ru) | 2011-04-08 | 2017-11-30 | Кр. Хансен А/С | Противомикробная композиция |
| JP6018171B2 (ja) * | 2011-04-08 | 2016-11-02 | セーホーエル.ハンセン アクティーゼルスカブ | フレーバー強化ラクトバチルス・ラムノサス |
| ES2630711T3 (es) * | 2012-04-09 | 2017-08-23 | Chr. Hansen A/S | Bioprotección utilizando cepas de Lactobacillus rhamnosus |
| PL2836588T3 (pl) * | 2012-04-09 | 2017-08-31 | Chr. Hansen A/S | Bioprotekcja z zastosowaniem szczepów Lactobacillus paracasei |
| CA2874421A1 (en) * | 2012-05-21 | 2013-11-28 | Dupont Nutrition Biosciences Aps | Strains of lactobacillus with antifungal properties |
| CN104855674A (zh) * | 2015-05-18 | 2015-08-26 | 上海佳俊生物科技有限公司 | 组合菌种联合转化的微生物发酵全价饲料生产方法 |
| EP3344749A1 (en) | 2015-08-31 | 2018-07-11 | Chr. Hansen A/S | Lactobacillus fermentum bacteria with antifungal activity |
| US20180235248A1 (en) | 2015-08-31 | 2018-08-23 | Chr. Hansen A/S | Lactobacillus fermentum bacteria inhibiting post-acidification |
| BR112018003474A2 (pt) * | 2015-08-31 | 2018-09-25 | Chr Hansen As | bactérias lactobacillus fermentum que reduzem a concentração de acetaldeído |
-
2016
- 2016-08-30 EP EP16759737.6A patent/EP3344749A1/en not_active Withdrawn
- 2016-08-30 CN CN201810426755.6A patent/CN108587968A/zh active Pending
- 2016-08-30 AU AU2016315133A patent/AU2016315133A1/en not_active Abandoned
- 2016-08-30 JP JP2018510815A patent/JP2018526993A/ja not_active Withdrawn
- 2016-08-30 EA EA201890404A patent/EA201890404A1/ru unknown
- 2016-08-30 BR BR122018013713-4A patent/BR122018013713B1/pt active IP Right Grant
- 2016-08-30 EP EP19172112.5A patent/EP3553166A1/en active Pending
- 2016-08-30 UA UAA201809178A patent/UA127431C2/uk unknown
- 2016-08-30 PE PE2018000327A patent/PE20181133A1/es unknown
- 2016-08-30 BR BR112018003018A patent/BR112018003018A2/pt not_active IP Right Cessation
- 2016-08-30 EA EA201891889A patent/EA037612B1/ru not_active IP Right Cessation
- 2016-08-30 US US15/755,023 patent/US20180249727A1/en not_active Abandoned
- 2016-08-30 CN CN201680059331.XA patent/CN108138124A/zh active Pending
- 2016-08-30 PE PE2021000842A patent/PE20211663A1/es unknown
- 2016-08-30 KR KR1020187008642A patent/KR20180042407A/ko not_active Withdrawn
- 2016-08-30 KR KR1020187025725A patent/KR20180101636A/ko not_active Ceased
- 2016-08-30 WO PCT/EP2016/070381 patent/WO2017037046A1/en not_active Ceased
- 2016-08-30 MX MX2018002278A patent/MX2018002278A/es unknown
- 2016-08-31 AR ARP160102649A patent/AR105866A1/es unknown
-
2018
- 2018-02-09 ZA ZA2018/00859A patent/ZA201800859B/en unknown
- 2018-02-22 IL IL257682A patent/IL257682A/en unknown
- 2018-06-19 AR ARP180101713 patent/AR112198A2/es unknown
- 2018-06-28 AU AU2018204698A patent/AU2018204698B2/en active Active
- 2018-07-05 ZA ZA2018/04542A patent/ZA201804542B/en unknown
- 2018-09-04 IL IL261588A patent/IL261588A/en unknown
- 2018-09-11 US US16/128,460 patent/US11096396B2/en active Active
- 2018-10-03 JP JP2018187992A patent/JP7094850B2/ja active Active
Also Published As
| Publication number | Publication date |
|---|---|
| JP2019013240A (ja) | 2019-01-31 |
| EP3553166A1 (en) | 2019-10-16 |
| JP7094850B2 (ja) | 2022-07-04 |
| ZA201800859B (en) | 2019-01-30 |
| EA201891889A1 (ru) | 2019-02-28 |
| IL257682A (en) | 2018-04-30 |
| MX2018002278A (es) | 2018-03-23 |
| US11096396B2 (en) | 2021-08-24 |
| IL261588A (en) | 2018-10-31 |
| AU2018204698B2 (en) | 2020-05-21 |
| CN108587968A (zh) | 2018-09-28 |
| AU2018204698A1 (en) | 2018-07-19 |
| JP2018526993A (ja) | 2018-09-20 |
| EA201890404A1 (ru) | 2018-09-28 |
| AR112198A2 (es) | 2019-10-02 |
| AR105866A1 (es) | 2017-11-15 |
| ZA201804542B (en) | 2019-09-25 |
| KR20180101636A (ko) | 2018-09-12 |
| EP3344749A1 (en) | 2018-07-11 |
| BR112018003018A2 (pt) | 2018-09-18 |
| CN108138124A (zh) | 2018-06-08 |
| US20190059406A1 (en) | 2019-02-28 |
| UA127431C2 (uk) | 2023-08-23 |
| US20180249727A1 (en) | 2018-09-06 |
| AU2016315133A1 (en) | 2018-03-08 |
| WO2017037046A1 (en) | 2017-03-09 |
| BR122018013713A2 (pt) | 2019-09-10 |
| PE20211663A1 (es) | 2021-08-26 |
| PE20181133A1 (es) | 2018-07-17 |
| BR122018013713B1 (pt) | 2024-01-23 |
| EA037612B1 (ru) | 2021-04-21 |
Similar Documents
| Publication | Publication Date | Title |
|---|---|---|
| JP7094850B2 (ja) | 抗真菌活性を有するラクトバチルス・ファーメンタム菌 | |
| EP2836587B1 (en) | Bioprotection using lactobacillus rhamnosus strains | |
| EP3344052B1 (en) | Lactobacillus fermentum bacteria inhibiting post-acidification | |
| JP6430930B2 (ja) | ラクトバチルス・パラカゼイ株を使用した生物防除 | |
| AU2018355721B2 (en) | Lactobacillus rhamnosus with increased diacetyl production | |
| KR20180042408A (ko) | 아세트알데히드의 농도를 감소시키는 락토바실러스 퍼멘텀 박테리아 | |
| JP2023527375A (ja) | 低い後酸性化を有する生物防除乳酸菌 |
Legal Events
| Date | Code | Title | Description |
|---|---|---|---|
| PA0105 | International application |
Patent event date: 20180327 Patent event code: PA01051R01D Comment text: International Patent Application |
|
| PG1501 | Laying open of application | ||
| A107 | Divisional application of patent | ||
| PA0104 | Divisional application for international application |
Comment text: Divisional Application for International Patent Patent event code: PA01041R01D Patent event date: 20180905 |
|
| PC1203 | Withdrawal of no request for examination |